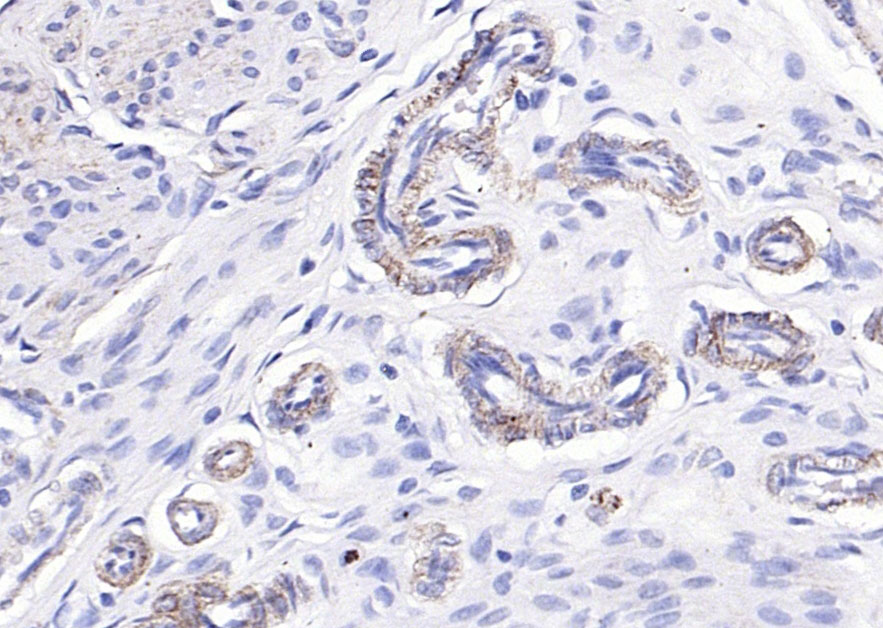
产品细节图片7

相关产品推荐更多 >
万千商家帮你免费找货
0 人在求购买到急需产品
- 详细信息
- 文献和实验
- 技术资料
- 应用范围:
产品信息以Bioss网站为准
- 规格:
50ul/100ul/200ul
| 规格: | 50ul | 产品价格: | ¥1180.0 |
|---|---|---|---|
| 规格: | 100ul | 产品价格: | ¥1980.0 |
| 规格: | 200ul | 产品价格: | ¥2800.0 |
| 产品编号 | bs-5548R |
| 英文名称 | phospho-Paxillin (Tyr88) Rabbit pAb |
| 中文名称 | 磷酸化桩蛋白Paxillin抗体 |
| 英文别名 | Paxillin(phospho Y88); p-Paxillin(phospho Tyr88); PXN(phospho Y88); p-paxillin; PXN(phospho Y88); Paxillin(phospho Y88); Paxillin(phospho Tyr88); p-Paxillin(Tyr88); Paired box protein Pax 1; PAX 1; PAX1; Paxillin alpha; PXN; PXN protein; FLJ16691; FLJ23042; FLJ16691; PAXI_HUMAN; Paxillin; PXN protein. |
| 产品应用 | WB=1:500-2000, IHC-P=1:100-500, IHC-F=1:100-500, IF=1:100-500 Not yet tested in other applications. |
| 交叉反应 | Human, Mouse, Rat |
| 抗体来源 | Rabbit |
| 免疫原 | KLH conjugated Synthesised phosphopeptide derived from human Paxillin around the phosphorylation site of Tyr88 |
| 亚型 | IgG |
| 性状 | Liquid |
| 纯化方法 | affinity purified by Protein A |
| 克隆类型 | Polyclonal |
| 理论分子量 | 68 kDa |
| 浓度 | 1mg/ml |
| 储存液 | 0.01M TBS (pH7.4) with 1% BSA, 0.02% Proclin300 and 50% Glycerol. |
| 研究领域 | Cancer > Signal transduction Signal Transduction > Adapters > Cytoplasmic Signal Transduction > Cytoskeleton / ECM > Extracellular Matrix > Structures > Focal Adhesions |
| 亚基 | Binds in vitro to vinculin as well as to the SH3 domain of SRC and, when tyrosine phosphorylated, to the SH2 domain of V-CRK. Isoform beta binds to PTK2/FAK1 but weakly to vinculin. Isoform gamma binds to vinculin but only weakly to PTK2/FAK1. Interacts with GIT1, NUDT16L1/SDOS, PARVA and TGFB1I1. Component of cytoplasmic complexes, which also contain GIT1, ARHGEF6 and PAK1. Interacts with PTK2/FAK1 and PTK2B/PYK2. Binds ASAP2. Interacts with unphosphorylated ITGA4. Interacts with RNF5 and PDCD10. Interacts with NEK3 and this interaction is prolactin-dependent. Interacts with PTK6. |
| 亚细胞定位 | Cytoplasm, cytoskeleton. Cell junction, focal adhesion. Cytoplasm, cell cortex. Note=Colocalizes with integrins at the cell periphery. |
| 翻译后修饰 | Phosphorylated by MAPK1/ERK2 (By similarity). Phosphorylated on tyrosine residues during integrin-mediated cell adhesion, embryonic development, fibroblast transformation and following stimulation of cells by mitogens. Phosphorylation at Ser-244 by CDK5 reduces its interaction with PTK2/FAK1 in matrix-cell focal adhesions (MCFA) during oligodendrocytes (OLs) differentiation. Phosphorylation at Tyr-31 and Tyr-118 by PTK6 promote the activation of RAC1 via CRK/CrKII, thereby promoting migration and invasion. |
| 相似性 | Belongs to the paxillin family.
Contains 4 LIM zinc-binding domains. |
| 功能 | Cytoskeletal protein involved in actin-membrane attachment at sites of cell adhesion to the extracellular matrix (focal adhesion). |
| 保存条件 | Shipped at 4℃. Store at -20℃ for one year. Avoid repeated freeze/thaw cycles. |
| 注意事项 | This product as supplied is intended for research use only, not for use in human, therapeutic or diagnostic applications. |
| 背景资料 | Paxillin is a 64 kDa cytoskeletal adapter protein involved in organisation and function of focal adhesions, which are critical to cell adhesion and migration. This in turn plays a role in a wide variety of processes including embryogenesis, organogenesis, wound repair, inflammation and cancer. Paxillin contains LD motifs, LIM domains, SH3 and SH2 binding domains that serve as docking sites for cytoskeletal proteins, tyrosine kinases (e.g., FAK, Pyk 2, Src), serine/threonine kinases, GTPase activating proteins and other adaptor proteins (e.g., Actin, Vinculin, Crk). |
| 应用 | 推荐稀释比例 |
| {WB} | {1:500-2000} |
| {IHC-P} | {1:100-500} |
| {IHC-F} | {1:100-500} |
| {IF} | {1:100-500} |

293T(Human) Cell Lysate at 30 ug
Primary: Anti-Phospho-Paxillin(Tyr88) (bs-5548R) at 1/500 dilution
Secondary: IRDye800CW Goat Anti-Rabbit IgG at 1/20000 dilution
Predicted band size: 68 kD
Observed band size: 68 kD

Embryo (Mouse) Lysate at 40 ug
Primary: Anti-Phospho-Paxillin(Tyr88) (bs-5548R) at 1/500 dilution
Secondary: IRDye800CW Goat Anti-Rabbit IgG at 1/20000 dilution
Predicted band size: 68 kD
Observed band size: 68 kD

风险提示:丁香通仅作为第三方平台,为商家信息发布提供平台空间。用户咨询产品时请注意保护个人信息及财产安全,合理判断,谨慎选购商品,商家和用户对交易行为负责。对于医疗器械类产品,请先查证核实企业经营资质和医疗器械产品注册证情况。
文献和实验[IF={{ 5.6 }}] {Ying Zhang. et al. Fyn-Mediated Paxillin Tyrosine 31 Phosphorylation Regulates Migration and Invasion of Breast Cancer Cells. INT J MOL SCI. 2023 Jan;24(21):15980} {WB} {Human}
[IF={{ 4.452 }}] {Jiang-Ni Wu. et al. SphK1-driven autophagy potentiates focal adhesion paxillin-mediated metastasis in colorectal cancer. 2021 Jul 16} {WB} {Human}
。所以,我们建议使用微波炉或高压锅加热煮沸以达到最佳抗原修复效果。抗体:Phospho–Stat3 (Tyr705)(D3A7) XP. Rabbit mAb #9145样本:石蜡包埋人类肺部肿瘤样本煮沸设备:浴锅 (左),微波炉 (中),高压锅 (右)免疫染色—封闭在 IHC–P 中,我们建议在室温下在含有 Tween20 的 TBST 缓冲液和 5% 正常山羊血清 (NGS) 中封闭样品,时长 1 小时,以防止非特异性背景染色。在进行 IHC–F 时,在含有 0.3% Triton. X–100 的 1X
used in accordance withmanufacturer recommendationsSignalStain?DAB Substrate Kit #8059:IHC analysis of paraffin-embedded human breastcarcinoma using Phospho-Stat3 (Tyr705) (D3A7) XP? Rabbit mAb #9145. Chromogenicdetection was performed using #8059 (left
v468. chapter 4 WNT 细胞通路 检测细胞GSK3活性与表达水平
. Immunoblot using antibodies to phospho-Tyr279/216 can assess alterations in activity independent ofthe N-terminal phosphorylation, although phosphorylation atthis site is most likely to be constitutive (14) . 3. Immunoblot using antibodies to known
技术资料暂无技术资料 索取技术资料









